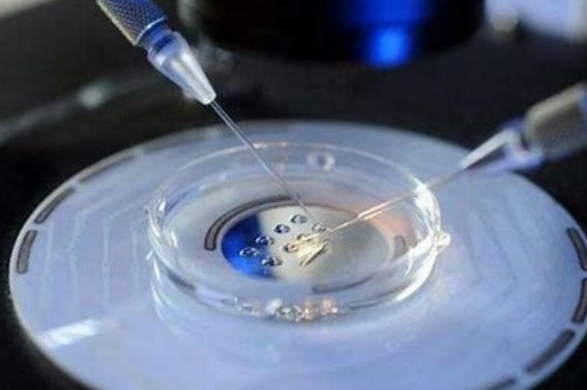

在试管婴儿备孕这一关键阶段,饮食的科学性和合理性对于提升成功率至关重要。合理的饮食不仅能够优化身体状态,还能显著提升卵子和精子的质量,从而增加受孕的机率。以下是一些专业的饮食注意事项:
一、确保营养均衡
备孕期间,饮食应多样化,确保涵盖各类营养成分。首要的是多吃富含膳食纤维的食物,如芹菜、莲藕、白菜和香蕉等,这些食物有助于促进肠道蠕动,预防便秘,确保肠道健康。同时,应适量摄入富含维生素A的食物,如胡萝卜、菠菜和甜椒,它们对于卵泡的形成和改善子宫内环境具有积极作用。
二、重视必要营养素的摄入
叶酸在试管婴儿备孕期间扮演着至关重要的角色,它能有效促进胚胎发育,并显著降低胎儿神经管缺陷的风险。因此,应多吃富含叶酸的食物,如绿叶蔬菜、豆类、坚果和肝脏。此外,铁和锌也是不可或缺的营养素,它们对提高卵巢功能和精子质量具有显著作用。红肉、海鲜和全谷物都是这些矿物质的优质来源。
三、规避不良饮食习惯
在备孕期间,应避免高脂肪、高热量和刺激性食物的摄入,如奶油、油炸食品、辛辣调料等。这些食物不仅不利于身体健康,还可能对卵子和精子的质量产生负面影响。同时,要减少咖啡因和酒精的摄入,并完全避免吸烟,这些不良习惯都会显著降低受孕成功率。
四、合理安排饮食时间
除了食物种类,饮食时间也需要注意。备孕期间应保持规律的饮食习惯,一日三餐定时定量,避免暴饮暴食。晚餐不宜过晚,以免影响睡眠质量和消化系统的正常工作。
五、个性化调整饮食习惯
每个人的身体状况和营养需求都有所不同,因此,在备孕期间,应根据个人情况对饮食习惯进行个性化调整。可以咨询专业的营养师或医生,制定适合自己的饮食计划。








